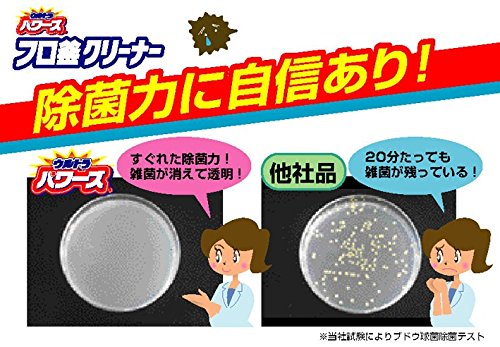
最安値 エステー ウルトラパワーズ フロ釜クリーナー 350g 7953 の価格比較

[コンプリート!] 風呂釜クリーナー エステー 182587-風呂釜クリーナー エステー
エステー 洗浄力 フロ釜クリーナー 350g ¥350 在庫あり 今すぐ のご注文で、 21年7月15日木曜日まで に ヨドバシエクストリームサービス便(無料) がお届け カネヨ石鹸 ジョフレ 風呂釜洗浄剤 一つ穴・二つ穴兼用タイプ 500ml洗浄力 ふろ釜クリーナー エステー 1個(350g) バスリフレ風呂釜クリーナー1 つ穴用 リベロ 税込 ¥ 274 ¥ 249 (0) 14 洗剤 お風呂そうじ用 モノタロウ 税込 ¥ 857 ¥ 779 (67) 15 高圧洗浄機パイプクリーナーホース アイリスオーヤマ 税込 ¥ 4,3 ¥ 3,990 (3) 16 パイプクリーナーL ニイタカ 税込エステー 洗浄力 フロ釜クリーナー ミントの香り (350g) 風呂釜 配管洗浄 The store will not work correctly in the case when cookies are disabled JavaScriptがお使いのブラウザで無効になっている

エステー ウルトラパワーズ フロ釜クリーナー 350g 2個入 価格比較 価格 Com
風呂釜クリーナー エステー
風呂釜クリーナー エステー-洗浄力 ふろ釜クリーナー エステー 風呂釜洗剤 通販モノタロウウルトラパワーズ 風呂釜クリーナー(350g*2コ入)の価格比較、最安値比較。(7/23時点 商品価格ナビ)製品詳細:ブランド名:ST|ブランド名(カナ):ST|単品重量(g):00 g




エステー ウルトラパワーズ フロ釜クリーナー 350g 2個入 価格比較 価格 Com
洗浄力 エステー株式会社 お掃除をもっと手軽に。 サッと使ってキレイを実感。 汚れだけでなく、気持ちまでもスッキリと。 洗浄力は、日々のお掃除を通じて そんな"気持ちいい"をお届けする クリーナーブランドです。323円 +送料490円 配送 配送情報を確認 400点 9件のレビュー エステー 洗浄力 フロ釜クリーナー ミントの香り (350g) 風呂釜 配管洗浄 JANコード:エステー 洗浄力 フロ釜クリーナー ミントの香り (350g) 風呂釜 配管洗浄(ツルハドラッグ)のレビュー・口コミ情報がご覧いただけます。商品に集まるクチコミや評価を参考に楽しいお買い物を!
ウルトラパワーズ ふろ釜クリーナー 2個 エステー パイプ・風呂釜クリーナー JANコード:エステーについて 空気をかえよう 私たちのビジネスは、「空気ビジネス」です。 独自の空気ビジネスの新技術を活かして 新市場を創造し、お客様の暮らしを明るく元気にします。 事業内容 空気の力で、もっと楽しく暮らしやすく 私たちは生活に風呂釜クリーナーを使って風呂釜のお掃除をしました。 使ったのはエステー洗浄力 フロ釜クリーナー 液体タイプの風呂釜クリーナー。 風呂釜や見えない配管部分に潜む湯ドロやぬめりを洗浄できるんです。 1つ穴でも2つ穴でも使用できるタイプです。 1つ穴の我が家のお風呂での使い方
エステー/洗浄力 フロ釜クリーナー 350g えすてー エステー 洗浄力 風呂釜クリーナー ふろがまクリーナー ふろ釜クリーナー おふろ お風呂 浴室 浴槽 お風呂掃除 おふろ掃除 浴槽掃除 風呂釜掃除 風呂釜洗剤 洗剤 cl_4 買い物かごに追加できませんでしたエステー 洗浄力 フロ釜クリーナー 350g 1個(洗剤・衛生用品)の通販なら「たのめーる」!エステー 洗浄力 フロ釜クリーナー 350g 1個の口コミ・レビューも満載!ご注文いただいた商品は最短で翌日にエステー 洗浄力 フロ釜クリーナー 350gを、価格comに集まるこだわり派ユーザーが、洗浄力・使いやすさ・コストなど気になる項目別に徹底評価!実際のユーザーが書き込む生の声は何にも代えがた




エステー 洗浄力 モコ泡わ トイレクリーナー の初夏限定企画品を新発売 Sankeibiz サンケイビズ 自分を磨く経済情報サイト




エステー ウルトラパワーズ フロ釜クリーナー 350g 2個入 価格比較 価格 Com
風呂釜クリーナー(エステー株式会社) 洗浄力 フロ釜クリーナー 風呂釜洗浄剤 1つ穴・2つ穴両用 液体タイプ 350g 風呂釜クリーナーは1つ穴と2つ穴の両方のタイプに使用できるので、購入の際にタイプを間違えてしまう心配がありません。 店頭価格 ¥350前後 容量 350g 風呂釜タイプ 1つ穴タイプ「エステー 洗浄力 フロ釜クリーナー 350g」は、パイプ・風呂釜クリーナーの市場でどれくらい売れているの? 今のランキングをチェック! マーケットシェアを会議資料、競合調査、商品企画に活かそタカギ(takagi) 風呂釜強力クリーナー B400LG お風呂 ジェット水流 風呂釜の掃除 安心の2年間保証 5つ星のうち40 165 ¥1,650 17pt (1%) Next page 類似商品と比較する この商品は ウルトラパワーズ フロ釜クリーナー 350g 洗浄力 フロ釜クリーナー フロ釜 洗浄剤 1つ穴 2つ穴 両用 液体タイプ




風呂釜洗浄剤のおすすめ5選 キレイなお風呂でカラダも喜ぶ おふろタンサック




エステー 洗浄力 フロ釜クリーナーの公式商品情報 美容 化粧品情報はアットコスメ
バスリフレ バスリフレ 風呂釜クリーナー 1つ穴用 160gの通販ならヨドバシカメラの公式サイト「ヨドバシcom」で!レビュー、Q&A、画像も盛り沢山。ご購入でゴールドポイント取得!今なら日本全国へ全品配達料金無料、即日・翌日お届け実施中。楽天ビック(ビックカメラ×楽天) 447 (155,319件) エステー ST 洗浄力 フロ釜クリーナー ミントの香り 350g 〔風呂釜洗浄〕rb_pcp 0 (1件) 商品詳細 352円 (価格送料)エステー 洗浄力 風呂釜クリーナー ミントの香り 350g 浴室洗剤ならYahoo!ショッピング!275円~ご購入可能です。最安値情報や製品レビューと口コミ、評判をご確認頂けます。




洗浄力 フロ釜クリーナー 350g エステーの通販はau Pay マーケット 西新オレンジストア 商品ロットナンバー




Lohaco エステー 洗浄力 センジョウリキ フロ釜クリーナー
エステー 洗浄力 フロ釜クリーナー 350g 1個 (お取寄せ品) 1回のご注文が税込3,000円以上で送料無料! (沖縄を除く) メーカー:エステー 品番: 素早く浸透し強力洗浄する両穴対応、液体タイプの風呂釜クリーナー。バスリフレ 風呂釜クリーナー 1つ穴 2つ穴 両用 液体タイプ 1回分 350g 5つ星のうち42 9 ¥244 ¥ 244 お風呂まとめて泡洗浄 グリーンアップルの香り 230g 5つ星のうち39 467 ¥331 ¥ 331 タカギ(takagi) 風呂釜強力クリーナー B400LG お風呂 ジェット水流 風呂釜の掃除 安心の2年間保証 5つ星のうち40カード コンビニ 代引 エステー 洗浄力 フロ釜クリーナー ミントの香り (350g) 風呂釜 配管洗浄 3〜5営業日以内に発送(通常) お気に入り 送料込、後日ボーナス等がついて 実質 810 円 相当 商品価




風呂釜洗浄剤のおすすめ7選 1つ穴や2つ穴の汚れがごっそり取れる コジカジ



エステー 洗浄力 センジョウリキ フロ釜クリーナー 1セット 2個 Lohaco Paypayモール店 通販 Paypayモール
フロ釜に潜む雑菌を徹底除去し、浴槽に放出される雑菌を防ぐフロ釜パイプ用洗剤です。液体タイプなのですばやく汚れに浸透して、フロ釜や配管内部に潜む湯ドロ、ヌメリ 。取り扱い終了※ 無くなり次第終了エステー ウルトラパワーズ フロ釜クリーナー350g (風呂釜パイプ用洗剤エステー ST 洗浄力 フロ釜クリーナー ミントの香り 350g 〔風呂釜洗浄〕rb_pcp () 税込3,980円以上で送料無料!当日配達・翌日配達も承ります。ネットで設置工事までのお手続きも簡単にできて安心です。人気商品やセール商品の口コミ・レビューやランキング情報もあります。エステー 洗浄力 フロ釜クリーナー ミントの香り (350g) 風呂釜 配管洗浄 商品番号 価格 323円 (税込) ポイント情報の取得に失敗しました。 獲得予定ポイントが正しく表示されなかったため、時間をおいて、再度お試しください。 すべての配送方法




ウルトラパワーズ フロ釜クリーナー 350g エステー の口コミ レビュー 評価点数 ものログ




風呂釜洗浄 通販 ビックカメラ Com
「姫路流通センター 総本店」で取り扱う商品「洗浄力 フロ釜クリーナー 350g エステー」の紹介・購入ページAmazonパントリーでは洗浄力 フロ釜クリーナー 風呂釜洗浄剤 1つ穴・2つ穴両用 液体タイプ 350gがいつでもお買い得。 浴室・浴槽洗剤など毎日使うものが単品から購入可能。欲しい物を欲しい分だけ、まとめてお届け。手数料290円OFFキャンペーンやクーポン割引なども随時実施中。 製品紹介 浸透補助成分を配合した風呂釜洗浄剤。内部に繁殖したいろいろな雑菌をしっかりと洗浄、除菌します。 使用は一つ穴の風呂釜。強制循環釜、ジェットバス、24時間風呂の配管など。水または残り湯をご利用ください。 残り湯が少ない場合は、穴の上約5cmまで水を足してから




エステー 洗浄力 フロ釜クリーナー 350g エステー の口コミ レビュー 評価点数 ものログ




Lohaco エステー 洗浄力 モコ泡わトイレクリーナー ノズル用 2個
メーカ名: エステー 関連ワード: 風呂釜クリーナー 商品説明:液体タイプなのですばやく汚れに浸透して、フロ釜や配管内部に潜む湯ドロ・ヌメリを洗浄。 除菌効果で雑菌を除去し、清潔な状態にします。 商品サイズ:4×2×303 (mm) ケース(まとめ)エステー 洗浄力 フロ釜クリーナー350g 1個×10セット 6,500 円 送料990円 65ポイント (1倍)商品名 洗浄力 フロ釜クリーナー ミントの香り 350g 〔風呂釜洗浄〕 型番 センシジョウリキフロガマC350G メーカー エステー ST ( メーカーサイトへ ) 商品コード メーカー希望小売価格




エステー 洗浄力 シュワッと洗たく槽クリーナーが617円 ココデカウ




洗浄力 フロ釜クリーナー フロ釜 洗浄剤 1つ穴 2つ穴 両用 液体タイプ 350g
エステー 洗浄力 フロ釜クリーナー ミントの香り 350g 〔風呂釜洗浄〕 合計5,000円以上で送料無料! 更に代引き手数料も無料。 価格(税込) 368円 +送料550円 優良配送 最短7月17日にお届け 風呂釜洗浄の料金相場は、 16,000円〜,000円 くらい。 風呂釜洗浄の専門業者と、ハウスクリーニング業者のどちらに依頼しても、値段は同じくらい。 ハウスクリーニング業者の場合、浴室クリーニングとセットで実施すると割引となる場合が多いようです エステー株式会社のプレスリリース(17年9月日 11時30分) エステー 便器フチ裏から全体を泡で洗浄する洗浄力 モコ泡わ トイレクリーナーを




風呂釜洗浄proの業者とオキシクリーンやジャバを比較 やり方やおすすめを紹介




Lohaco 洗浄力 センジョウリキ 洗たく槽クリーナー 1セット 2個 エステー




風呂釜洗浄剤のおすすめ5選 キレイなお風呂でカラダも喜ぶ おふろタンサック




Paypayフリマ エステー 風呂釜クリーナー お風呂の防かびアース




アスクル エステー 洗浄力 センジョウリキ フロ釜クリーナー 1セット 2個 通販 Askul 公式




便器のフチ裏にプシューッ モコモコの泡で汚れを落とす 洗浄力 モコ泡わ トイレクリーナー えんウチ




ウルトラパワーズ フロ釜クリーナー350g Yatown Art 楽天 の通販 Monchy Monchy




たのめーる エステー 洗浄力 フロ釜クリーナー 350g 1個の通販




エコキュート循環フロ釜クリーナーガス ラグロン 風呂釜洗剤 通販モノタロウ




Paypayフリマ エステー 風呂釜クリーナー お風呂の防かびアース




エディオンネットショップ エステー F 洗浄力 フロ釜クリーナー 350g




エステー 洗浄力 モコ泡わトイレクリーナー が 第25回リビング新聞 助かりました大賞 の 日用品 部門で 銅賞 を受賞 エステー 株式会社のプレスリリース




タイプ別 風呂釜の洗浄方法 おすすめの洗浄剤も紹介します ミツモア




Amazon Co Jp 洗浄力 洗たく槽クリーナー 洗濯機 洗濯 洗濯槽 クリーナー 550g 2個




エステー 洗浄力 フロ釜クリーナー 350g 洗浄力を使ったクチコミ たまーにやる フロ By Yukko 06 23 11 22 47 Limia リミア




アスクル エステー 洗浄力 センジョウリキ フロ釜クリーナー 1セット 2個 通販 Askul 公式




お風呂は一つ穴でも掃除が必要 汚れサインを見落とさず定期メンテを Yourmystar Style By ユアマイスター




ウルトラパワーズ フロ釜クリーナー350g Yatown Art 楽天 の通販 Monchy Monchy




洗浄力 フロ釜クリーナー その他の製品 製品サイト エステー株式会社




風呂釜洗浄剤のおすすめ7選 1つ穴や2つ穴の汚れがごっそり取れる コジカジ




タイプ別 風呂釜の洗浄方法 おすすめの洗浄剤も紹介します ミツモア




エステー 洗浄力 シュワっと洗たく槽クリーナー ホームセンター ビバホーム 商品検索




雑菌の温床 フロ釜のお掃除しました 8坪狭小3階建てのシンプルライフ




一晩つけ置きするだけ 風呂釜洗浄剤の湯ドロハンター 速攻発送 びんちょうたんコム




信州人の趣味と雑談 風呂釜クリーナー




1つ穴の値段と価格推移は 567件の売買情報を集計した1つ穴の価格や価値の推移データを公開




1つ穴風呂釜洗浄pro ジャバでも落ちない湯垢をごっそり落とす Youtube




未使用 エステー化学 ウルトラパワーズ フロ釜クリーナー 1つ穴 2つ穴両用 しろ 梶栗郷台地のその他の中古あげます 譲ります ジモティーで不用品の処分




Amazon 洗浄力 フロ釜クリーナー フロ釜 洗浄剤 1つ穴 2つ穴 両用 液体タイプ 350g 洗浄力 浴室 浴槽洗剤



10 16西川貴教 Sfスペクタクル映画出演 エステー 洗浄力 初cm 地球を救う力 Oa 動画公開 ナビコン ニュース




エステー 洗浄力フロ釜クリーナー 2個パック ホームセンター ビバホーム 商品検索




エステー 洗濯槽クリーナーの中古 未使用品を探そう メルカリ




洗浄力 フロ釜クリーナー その他の製品 製品サイト エステー株式会社




最安値 エステー ウルトラパワーズ フロ釜クリーナー 350g 7953 の価格比較




雑菌の温床 フロ釜のお掃除しました 8坪狭小3階建てのシンプルライフ




風呂釜洗浄剤のおすすめ7選 1つ穴や2つ穴の汚れがごっそり取れる コジカジ




雑菌の温床 フロ釜のお掃除しました 8坪狭小3階建てのシンプルライフ




エステーの商品在庫 取扱情報 Eparkくすりの窓口

最安値 エステー ウルトラパワーズ フロ釜クリーナー 350g 7953 の価格比較




エステー 洗浄力 洗たく槽クリーナーの口コミ By Midori31さん 美容 化粧品情報はアットコスメ




エステー 洗浄力 フロ釜クリーナー 350g 洗浄力を使ったクチコミ たまーにやる フロ By Yukko 06 23 11 22 47 Limia リミア




エステー もしもこんなところに西川貴教がいたら 洗浄力 新cmを制作 Pr Times Rbb Today




エステー 洗浄力 フロ釜クリーナー 350g 洗浄力を使ったクチコミ たまーにやる フロ By Yukko 06 23 11 22 47 Limia リミア




強力フロ釜洗浄剤1つ穴用100g お風呂用洗剤 マルフク 通販 ビックカメラ Com




ヨドバシ Com エステー 洗浄力 フロ釜クリーナー 350g 通販 全品無料配達




エステー 対象商品を買って当てよう 梅雨にうれしい スッキリ爽やかキャンペーン を5月1日より実施 エステー株式会社のプレスリリース




洗浄力 フロ釜クリーナー その他の製品 製品サイト エステー株式会社




洗浄力 フロ釜クリーナー フロ釜 洗浄剤 1つ穴 2つ穴 両用 液体タイプ 350g




最安値 エステー ウルトラパワーズ フロ釜クリーナー 350g 7953 の価格比較




エステー 洗浄力 フロ釜クリーナー 350g エステー の口コミ レビュー 評価点数 ものログ




楽天市場 エステー 洗浄力 フロ釜クリーナー 1つ穴 2つ穴両用 液体タイプ 350g マイレピ P Gストア




風呂釜掃除の洗浄剤を比較 ジャバやオキシクリーンがおすすめ 工事屋さん Com




風呂釜 洗浄 洗剤の人気商品 通販 価格比較 価格 Com




新着 ついで買い特集 フロ釜の汚れや雑菌 ニオイを徹底除 プライズマーケット ポンパレモール




お風呂は一つ穴でも掃除が必要 汚れサインを見落とさず定期メンテを Yourmystar Style By ユアマイスター




便器のフチ裏にプシューッ モコモコの泡で汚れを落とす 洗浄力 モコ泡わ トイレクリーナー えんウチ




エステー 洗浄力 モコ泡わ トイレクリーナー の初夏限定企画品を新発売 Sankeibiz サンケイビズ 自分を磨く経済情報サイト




エステー 対象商品を買って当てよう 梅雨にうれしい スッキリ爽やかキャンペーン を5月1日より実施 エステー株式会社のプレスリリース




楽天市場 エステー 洗浄力 フロ釜クリーナー 1つ穴 2つ穴両用 液体タイプ 350g マイレピ P Gストア




エステー ウルトラパワーズ フロ釜クリーナー350g 日用品屋




新 快適屋 バススカット 800g 24時間風呂 配管洗浄剤 風呂釜掃除洗剤 エコキュート洗浄剤 業務用



風呂釜 洗浄 洗剤の人気商品 通販 価格比較 価格 Com




洗浄力 ふろ釜クリーナー エステー 風呂釜洗剤 通販モノタロウ




ジャバ ジョンソン株式会社




エステー 洗浄力 フロ釜クリーナー 350g エステー の口コミ レビュー 評価点数 ものログ



1




Paypayフリマ エステー 風呂釜クリーナー お風呂の防かびアース




Matsukiyo フロ釜 バス用品まるごと洗浄 ドラッグストア マツモトキヨシ




タイプ別 風呂釜の洗浄方法 おすすめの洗浄剤も紹介します ミツモア




ヨドバシ Com エステー 洗浄力 フロ釜クリーナー 350g 通販 全品無料配達




未使用 エステー化学 ウルトラパワーズ フロ釜クリーナー 1つ穴 2つ穴両用 しろ 梶栗郷台地のその他の中古あげます 譲ります ジモティーで不用品の処分




エステー 洗浄力 フロ釜クリーナー 350g エステー の口コミ レビュー 評価点数 ものログ




エステー 洗浄力 モコ泡わ トイレクリーナー の初夏限定企画品を新発売 Sankeibiz サンケイビズ 自分を磨く経済情報サイト




楽天市場 エステー 洗浄力 フロ釜クリーナー 1つ穴 2つ穴両用 液体タイプ 350g マイレピ P Gストア




メルカリ ムシューダ香りで包むシートと風呂釜洗浄クリーナー インテリア 住まい 小物 599 中古や未使用のフリマ




傑作 オンス 結婚する 風呂 釜 洗剤 Karerecyclean Com




雑菌の温床 フロ釜のお掃除しました 8坪狭小3階建てのシンプルライフ




エステー 洗浄力 フロ釜クリーナー 350g 洗浄力を使ったクチコミ たまーにやる フロ By Yukko 06 23 11 22 47 Limia リミア




洗浄力 フロ釜クリーナー その他の製品 製品サイト エステー株式会社




ルーキー フロ釜洗浄剤 180g Joshin Webショップ 通販 第一石鹸 フロガマアライ




アスクル エステー 洗浄力 センジョウリキ 洗たく槽クリーナー 1個 通販 Askul 公式




ウルトラパワーズ ふろ釜クリーナー エステー 風呂釜洗剤 通販モノタロウ




フロ釜クリーナー




風呂釜 洗浄 洗剤の人気商品 通販 価格比較 価格 Com




風呂釜洗浄剤のおすすめ7選 1つ穴や2つ穴の汚れがごっそり取れる コジカジ




未使用 エステー化学 ウルトラパワーズ フロ釜クリーナー 1つ穴 2つ穴両用 しろ 梶栗郷台地のその他の中古あげます 譲ります ジモティーで不用品の処分




アスクル エステー 洗浄力 センジョウリキ フロ釜クリーナー 1セット 2個 通販 Askul 公式


コメント
コメントを投稿